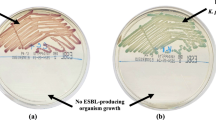

Abstract
Antimicrobial resistance (AMR) is a growing global public health concern, with contamination of poultry meat by multidrug-resistant and extended-spectrum beta-lactamase (ESBL)-producing Escherichia coli (E. coli) posing serious risks to food safety and public health. Therefore, this study aimed to isolate and characterize the multidrug-resistant E. coli harboring β-lactam resistance genes from raw Sonali chicken meat samples collected from retail poultry shops across six upazilas of the Narsingdi district in Bangladesh. A total of 390 meat swab samples were collected and analyzed between July and December 2023. E. coli was detected in 68.21% of the isolates, with 7.89% classified as enteropathogenic E. coli (EPEC) and 92.11% as non-EPEC. Antimicrobial susceptibility testing by disc diffusion method revealed complete resistance to ampicillin (100%), with high resistance to erythromycin (87.59%) and third-generation cephalosporins. Furthermore, the lowest resistance was observed for amoxicillin-clavulanate (3.01%). ESBL production was identified in 41.73% of the isolates. On the other hand, non-EPEC strains showed a significantly higher prevalence of ESBL production (p < 0.05). Genotypic analysis of β-lactamase genes in ESBL-positive isolates demonstrated that blaTEM (63.06%) and blaCTX-M-2a (60.36%) were the most prevalent. Additionally, co-occurrence of multiple β-lactamase genes was observed in 54.95% of isolates, with blaTEM, blaCTX-M-2a, and blaOXA-1 being the most common combination. Furthermore, resistance genes for AmpC (blaCMY, 27.07%) and metallo-β-lactamase (blaNDM-1, 9.02%) were exclusively detected in non-EPEC isolates. Significant positive correlations were observed among β-lactamase genes, highlighting the complexity of resistance mechanisms. Our results demonstrate the necessity of judiciously using antibiotics in Sonali chickens to prevent the emergence of resistant bacterial strains.
Similar content being viewed by others
Introduction
Antimicrobial resistance (AMR) has become a global public health concern, posing a substantial challenge to both human and animal health by reducing the effectiveness of current antimicrobial treatments. The World Health Organization (WHO) has recognized AMR as one of the top ten global health threats worldwide, underscoring the urgency of addressing this issue1. The rising demand for meat has driven extensive antibiotic use in livestock farming, particularly in poultry, increasing the prevalence of resistant bacteria including Escherichia coli (E. coli) in meat and meat products2,3. These resistant bacteria along with their genes can transmit to humans, presenting a serious public health concern.
E. coli, a member of the Enterobacteriaceae family, is commonly found in the gut microbiota of healthy animals and humans as a commensal. However, it can act as an opportunistic pathogen with multiple pathotypes, such as enterotoxigenic E. coli (ETEC), enteropathogenic E. coli (EPEC), extraintestinal pathogenic E. coli (ExPEC), and Shiga toxin-producing E. coli(STEC)4,5. These pathotypes are known to cause diseases in both humans and animals, with EPEC posing particular risks of severe diarrhea in infants in lower-middle-income countries6. Poultry, often identified as a potential reservoir for these pathotypes, consequently elevates the risk of zoonotic transmission7,8.
β-lactam antibiotics, including penicillin and its derivatives- cephalosporins, and carbapenems, are widely used against bacterial infections9. However, E. coli frequently produces β-lactamase enzymes as a primary defense, which inactivate these antibiotics10. The predominant β-lactamases in gram-negative bacteria include TEM, SHV, OXA, and CTX-M, with CTX-M now recognized as the most widespread enzyme11. Initially, the blaTEM and blaSHV were narrow-spectrum β-lactamase genes, conferring resistance to penicillins. However, mutations have led to extended-spectrum β-lactamases, which hydrolyze third-generation cephalosporins12. The blaOXA genes encode oxacillinase-type β-lactamases, some of which, like blaOXA-48, have evolved into carbapenemases, posing a significant treatment challenge13. The blaCTX-M genes, originating from Kluyvera species, have now surpassed blaTEM and blaSHV as the most prevalent ESBL genes globally, encoding enzymes with high activity against cefotaxime and ceftazidime14. Resistance genes for the β-lactamase enzymes are often plasmid-encoded, facilitating the spread across bacterial populations by horizontal transfer15. The spread of β-lactamase-producing organisms has emphasized the need for a “One Health” approach to AMR management16.
In Bangladesh, poultry constitutes 37% of total meat production, with chicken being the primary contributor17,18. Narsingdi is one of the major poultry-producing districts with an estimated population of 8,439,646 chickens, being the highest in Dhaka division and crucial for assessing antimicrobial resistance trends in poultry19. Among the many chicken breeds, Sonali– a crossbreed between Rhode Island Red and Fayoumi chickens, is particularly popular due to its hardiness and consumer preference over broiler meat20,21. However, there is limited research specifically addressing AMR in Sonali chicken meat, despite studies indicating poultry as a reservoir for β-lactamase-producing E. coli22. Considering these, this study aimed to investigate the prevalence of enteropathogenic and β-lactamase-producing E. coli isolated from Sonali chicken meat in Narsingdi district of Bangladesh. The study also aimed to evaluate the antibiotic resistance patterns, and identify genes associated with β-lactam antibiotic resistance, specifically ESBL genes (blaTEM, blaCTX-M, blaCTX-M-1, blaCTX-M-2a, blaSHV, blaOXA-1), AmpC gene (blaCMY), and MBL gene (blaNDM-1) present in the isolated E. coli.
Materials and methods
Study area and sample size
The study was conducted in six upazilas of Narsingdi district in Bangladesh, namely Belabo, Monohardi, Narsingdi Sadar, Palash, Raipura, and Shibpur (Fig. 1). A total of 390 meat swab samples (65 from each upazila) were collected from Sonali chickens, randomly selected from poultry retail shops, between July 2023 and December 2023. The sample size was determined using a previously reported prevalence rate of 66.8% by Ranasinghe et al.23, with a 5% precision and 95% confidence interval using Thrusfield’s formula:
where, n = the sample size, Z = 1.96, P = 0.668, and the level of precision, d = 0.05. The calculated sample size was 340, which was increased to 390 to enhance precision.
Isolation and identification of E. coli
The isolation and identification of E. coli were performed by growth on different culture media (nutrient broth, MacConkey agar, and EMB agar), different biochemical tests (sugar fermentation test, along with indole and methyl red (MR) tests, Voges-Proskauer (VP), and citrate utilization tests) and Gram-staining as previously described24.
Preparation, preservation, and re-culturing of E. coli from stock culture
Pure E. coli isolates were preserved in 50% sterilized glycerin in cryovials. For re-culturing, cryovials were equilibrated to room temperature and 10 µL of stock culture was transferred into a Falcon tubes containing 5 mL of nutrient broth and incubated at 37 °C for 24 h, resulting in visible turbidity, confirming bacterial growth. Cultures were vortexed briefly and samples were prepared for DNA extraction.
Extraction of bacterial genomic DNA
The extraction of bacterial DNA was performed using the boiling method, as previously described with slight modification4. Briefly, freshly grown E. coli broth culture (1 mL) was centrifuged at 10,000 rpm for 5 min, and the supernatant was discarded. The process was repeated, and 100 µL of nuclease-free water (NFW) was then added to the pellet, vortexed, and heated at 97 °C for 10 min. After cooling at −4 °C, the sample was centrifuged, and approximately 90 µL of supernatant containing DNA was stored at −20 °C.
Detection of enteropathogenic E. coli (EPEC) and non-enteropathogenic E. coli (non-EPEC) by PCR
Following the extraction of DNA, the isolates were screened for enteropathogenic E. coli (EPEC) by targeting the eaeA gene (Table 1). Amplification was performed in a 13 µL reaction mixture, including 6.5 µL of PCR master mix, 1 µL each of forward and reverse primers (10 µM), 1.5 µL of NFW, and 3 µL of template DNA, with the final concentration of each primer in the reaction mixture being 0.77 µM, using a specific thermal cycle (DLAB TC1000-G, USA) (Table S6). PCR products were visualized on a 2% agarose gel (SeaKem LE Agarose) using ethidium bromide (10 mg/mL), under UV light after electrophoresis at 100 V for 45 min.
Antimicrobial susceptibility test (AST)
Both the EPEC and non-EPEC isolates were tested for AST using the Kirby-Bauer disc diffusion method on Mueller–Hinton (MH) agar plates, following the Clinical and Laboratory Standards Institute (CLSI, 2020) guidelines25. The bacterial concentrations were standardized to a 0.5 McFarland standard and spread on the agar. Isolates were tested against 12 commonly used antibiotics: ampicillin (10 µg), amoxicillin-clavulanate (20/10 µg), Erythromycin (15 µg), ceftazidime (30 µg), cefpodoxime (10 µg), ceftriaxone (30 µg), gentamicin (10 µg), tetracycline (30 µg), ciprofloxacin (5 µg), levofloxacin (5 µg), co-trimoxa-sulphate (25 µg), and chloramphenicol (30 µg). The antibiotics were selected based on their frequent use in veterinary and human medicine, and significance in antimicrobial resistance surveillance. The selection was guided by CLSI guidelines, World Health Organization (WHO) medically important antimicrobials list26. The results were interpreted as susceptible, intermediate, or resistant (Table S2). Isolates that exhibited resistance to at least three antibiotic classes were considered multi-drug resistant (MDR).
ESBL detection by double disc synergy test (DDST)
The isolates resistant to third-generation cephalosporins (ceftriaxone, cefpodoxime, and ceftazidime) were tested for ESBL production using the DDST method. The test employed discs of amoxicillin/clavulanate (20 µg/10 µg), ceftriaxone (30 µg), ceftazidime (30 µg), and cefpodoxime (30 µg). These discs were placed 30 mm apart from the amoxicillin/clavulanate disc (center to center) and incubated at 37°C for 24 h. A positive result was indicated by reduced susceptibility to ceftriaxone, ceftazidime, or cefpodoxime, accompanied by a clear enhancement of the inhibition zone toward the amoxiclav disc.
Detection of β-lactam resistance genes in ESBL-positive isolates of E. coli by multiplex PCR
For the detection of β-lactam resistance genes in ESBL-positive E. coli isolates, we performed a multiplex PCR using multiple primer sets targeting different β-lactam resistance genes (Table 2). Primer set 2 targeted four ESBL genes (blaTEM, blaCTX-M, blaCTX-M1, and blaCTX-M-2a), primer set 3 targeted two additional ESBL genes (blaSHV and blaOXA-1), and primer set 4 targeted AmpC gene (blaCMY) and one MBL gene (blaNDM-1). The multiplex PCR was conducted in a total volume of 12.5 µL reaction mix (Tables S4-S5) using specific thermal cycling conditions for each of the primer sets (Tables S7-S9). The amplified PCR products were visualized on a 2% agarose gel, as previously described, to confirm the presence of β-lactam resistance genes in ESBL-positive isolates of E. coli.
Statistical analysis
Data were organized in Microsoft Office Excel 2021 (version 21.08), and statistical analyses were conducted in R (v4.3.1). The Chi-squared test of independence was executed to identify any significant association in the prevalence of E. coli across upazilas, with Fisher’s exact test performed when more than 20% of the cells had expected frequencies less than five. A significance level of p < 0.05 was considered as statistically significant. The pheatmap package generated a phenotypic resistance heatmap, and Spearman correlations were calculated and visualized with corrplot.
Prevalence of E. coli or ARGs \(=\frac{\text{Total number of }E. coli\text{ or ARGs}}{\text{Total number of sample or }E. coli\text{ isolates }}\times 100\)
Results
Prevalence of EPEC and non-EPEC isolated from Sonali chicken meat
Of the 390 tested meat swab samples, E. coli was detected in 266 isolates (68.21%) by initial cultural, biochemical, and gram staining methods (Figure S1). Among these, 21 isolates (7.89%) were identified as EPEC utilizing uniplex PCR targeting the eaeA gene, while the remaining 245 isolates (92.11%) were classified as non-EPEC (Fig. 2, Figure S5 and Table S11).
Gel documentation of uniplex PCR using primer set 1 for the detection of EPEC strains targeting eaeA gene of E. coli isolated from Sonali chicken meat (image cropped for clarity). Lane 1 = 1500 bp DNA ladder, lane 2 = negative control, lane 3 = positive control, and lanes 4–8 = E. coli isolates identified as EPEC. The original gel image is presented in supplementary figure S5.
Antibiogram profile of E. coli isolated from Sonali chicken meat
We studied the antibiogram profile of E. coli isolated from Sonali chicken meat (Fig. 3), which revealed that all the isolates (100%) were resistant to ampicillin. Nonetheless, higher resistance rates were observed in erythromycin (87.59%), cefpodoxime (84.59%), ceftazidime (83.08%), and co-trimoxa-sulphate (74.44%). In contrast, the lowest resistance rate was determined in amoxicillin-clavulanate (3.01%), followed by ciprofloxacin (12.78%), and ceftriaxone (13.53%). Intermediate resistance was noted in gentamicin (28.57%), chloramphenicol (43.61%), and tetracycline (60.90%).
Overall antibiogram profile of E. coli isolated from Sonali chicken meat in this study. (Abbreviations: AMP = ampicillin, AMC = amoxicillin-clavulanate, E = erythromycin, CAZ = ceftazidime, CPD = cefpodoxime, CTR = ceftriaxone, GEN = gentamicin, TE = tetracycline, CIP = ciprofloxacin, LE = levofloxacin, COT = co-trimoxa-sulphate, C = chloramphenicol).
Resistance profile of EPEC and non-EPEC
We further categorized the antibiogram profile of E. coli from Sonali chicken meat into EPEC and non-EPEC, classifying them as resistant (Fig. 4), intermediate, or sensitive (Figures S2 and S3). We found that all isolates (100%) were resistant to ampicillin, with high resistance to erythromycin (87.59%), cefpodoxime (84.59%), and ceftazidime (83.08%), and the lowest resistance to amoxicillin-clavulanate (3%). EPEC isolates exhibited high resistance to erythromycin (90.48%) and co-trimoxazole (76.19%), but lower resistance to cefpodoxime (57.14%) and ceftriaxone (0%) compared to non-EPEC isolates.
Non-EPEC isolates had higher resistance to cefpodoxime (86.94%) and lower resistance to ciprofloxacin (10.20%) and chloramphenicol (41.63%). Statistical analysis revealed significant associations between pathotype and resistance rates for amoxicillin-clavulanate (p < 0.05), cefpodoxime (p < 0.01), ciprofloxacin (p < 0.001), and chloramphenicol (p < 0.05).
Phenotypic resistance profile
A total of 51 distinct phenotypic resistance patterns were observed among the E. coli isolates (Fig. 5). The most common pattern, AMP-E-CAZ-CPD-TE-COT, was found in 55 isolates, followed by AMP-E-CAZ-CPD in 22 isolates, AMP-E-CAZ-CPD-C in 15 isolates, and AMP-E-CAZ-CPD-GEN-COT in 11 isolates. These resistance patterns are summarized in a heatmap (Fig. 5). Hierarchical clustering showed that E. coli isolates were more sensitive to chloramphenicol, gentamicin, ceftriaxone, levofloxacin, amoxicillin-clavulanate, and ciprofloxacin, while they were comparatively more resistant to ampicillin, cefpodoxime, erythromycin, ceftazidime, tetracycline, and co-trimoxazole.
Heatmap showing the phenotypic resistance profile with clustering of antibiotics and E. coli isolates from Sonali chicken meat. (Abbreviations: AMP = ampicillin, AMC = amoxicillin-clavulanate, E = erythromycin, CAZ = ceftazidime, CPD = cefpodoxime, CTR = ceftriaxone, GEN = gentamicin, TE = tetracycline, CIP = ciprofloxacin, LE = levofloxacin, COT = co-trimoxa-sulphate, and C = chloramphenicol).
Prevalence of ESBL-producing E. coli isolates based on DDST
Out of the 266 E. coli isolates, we found that 111 (41.73%) were positive for ESBL based on the DDST (Fig. 6). Among the EPEC isolates, only 3 (14.29%) tested positive for ESBL, while 108 (44.08%) of the non-EPEC isolates were ESBL-positive. We observed a significant difference (p < 0.05) between the rate of ESBL-positive isolates and their pathotypes, with non-EPEC isolates being significantly more positive for ESBL production compared to the EPEC isolates. The prevalence of ESBL-producing E. coli between EPEC and non-EPEC groups across six different upazilas of the Narsingdi district is demonstrated in Figure S4.
Prevalence of β-lactam antibiotic resistance genes in E. coli
We investigated the prevalence of β-lactam antibiotic resistance genes in E. coli, including six ESBL genes and one each of the AmpC and MBL genes, among EPEC and non-EPEC isolates. The prevalence of these resistance genes across EPEC and non-EPEC isolates from six upazilas of the Narsingdi district, Bangladesh, is further detailed in supplementary tables S12–S17.
ESBL genes
We investigated the prevalence of β-lactam resistance genes in E. coli, specifically targeting ESBL genes. Four ESBL genes were targeted using primer set 2 (Fig. 7 and Figure S6), while two additional ESBL genes were targeted with primer set 3 (Fig. 8 and Figure S7). Out of 111 ESBL-positive isolates, we found that 70 (63.06%) carried the blaTEM gene. Interestingly, all three ESBL-positive EPEC isolates harbored the blaTEM gene. However, none of the 111 isolates were positive for the blaCTX-M gene. We found that none of the ESBL-positive EPEC isolates carried the blaCTX-M, blaCTX-M-1, or blaCTX-M-2a genes. Among the non-EPEC isolates, 32 (29.63%) were positive for blaCTX-M-1, and 67 (62.03%) were positive for blaCTX-M-2a. The blaSHV gene was present in 27.78% of the 108 ESBL-positive non-EPEC isolates, while no blaSHV gene was found in EPEC isolates. For blaOXA-1, no EPEC isolates were positive, but 41.67% of non-EPEC isolates carried the gene.
Gel documentation of multiplex PCR using primer set 2 for detecting four ESBL genes of E. coli (blaTEM, blaCTX-M, blaCTX-M-1, and blaCTX-M-2a) isolated from Sonali chicken meat (image cropped for clarity). Lane 1 = 1500 bp DNA ladder; lane 2 = negative control; lane 3 = blaTEM (964 bp) & blaCTX-M-2a (397 bp); lane 4 = blaTEM (964 bp); lane 5 = blaCTX-M-1 (863 bp); lane 6 = blaTEM (964 bp); lane 7 = blaCTX-M-2a (397 bp); lane 8 = blaTEM (964 bp), blaCTX-M-1 (863 bp), and blaCTX-M-2a (397 bp). The original gel image is presented in supplementary figure S6.
Gel documentation of multiplex PCR using primer set 3 for detecting two ESBL genes of E. coli (blaSHV and blaOXA-1) isolated from Sonali chicken meat (image cropped for clarity). Lane 1 = 1500 bp DNA marker; lane 2 = negative control; lane 3 = blaSHV (795 bp); lane 4 = blaSHV (795 bp) & blaOXA-1 (564 bp); lane 5 = blaOXA-1 (564 bp); lane 6 = blaSHV (795 bp) & blaOXA-1 (564 bp); lane 7 = blaSHV (795 bp); lane 8 = negative sample. The original gel image is presented in supplementary figure S7.
AmpC and MBL genes
We examined the prevalence of AmpC and MBL genes in E. coli (Fig. 9 and Figure S8). We screened all the E. coli isolates (n = 266) by PCR assay, of which 72 (27.07%) isolates were found positive for the blaCMY gene, and all of them were non-EPEC strains. Additionally, the blaNDM-1 gene was identified in 24 (9.02%) isolates, all of which were non-EPEC strains.
Gel documentation of multiplex PCR using primer set 4 for detection of one AmpC (blaCMY) and one MBL (blaNDM-1) gene of E. coli isolated from Sonali chicken meat (image cropped for clarity). Lane 1 = 1500 bp DNA ladder; lane 2 = negative control; lane 3, 5, 6 & 8 = blaNDM-1 (465 bp); lane 4 & 7 = blaCMY (1007 bp). The original gel image is presented in supplementary figure S8.
Overall genotypic prevalence of β-lactamase genes in E. coli isolated from Sonali chicken meat
The overall genotypic prevalence of β-lactamase genes in E. coli isolated from Sonali chicken meat is summarized in Fig. 10. Among the β-lactamase genes, blaTEM emerged as the most prevalent detected in 63.06% of the isolates, closely followed by blaCTX-M-2a at 60.36%. The blaOXA-1 gene was present in 40.54% of the isolates, while blaCTX-M-1 and blaSHV were detected in 28.83% and 27.03% respectively. The blaCMY was identified in 27.07% of isolates, and blaNDM-1 appeared in 9.02%. Interestingly, none of the isolates were positive for the blaCTX-M gene.
Co-occurrence of β-lactamase genes of E. coli isolated from Sonali chicken meat
The co-occurrence of β-lactamase genes in E. coli isolated from Sonali chicken meat is summarized in Table 3. Among the 111 phenotypically ESBL-positive isolates, we found that all carried at least one ESBL gene. Multiple β-lactamase genes co-existed in 61 (54.95%) isolates, with the most common combination being three genes (blaTEM, blaCTX-M-2a, blaOXA-1) found in 21.62% of the isolates (Table 3). This was followed by two genes (blaTEM, blaCTX-M-2a) in 15.32%, four genes (blaTEM, blaSHV, blaCTX-M-1, blaCTX-M-2a) in 10.81%, and five genes (blaTEM, blaSHV, blaCTX-M-1, blaCTX-M-2a, blaOXA-1) in 7.21% of isolates (Table 3). Interestingly, co-occurrence of ESBL and MBL genes was observed in 6 (2.26%) isolates, all of which were non-EPEC strains.
Correlation between co-existing β-lactamase genes
The correlation between co-existing β-lactamase genes is shown in Fig. 11. We found a strong positive correlation between blaTEM and blaCTX-M-2a, as revealed by the Spearman correlation coefficient. Additionally, positive correlations were observed between blaSHV and blaCTX-M-1, blaNDM-1 and blaOXA-1, blaOXA-1 and blaCTX-M-2a, and blaOXA-1 and blaTEM.
Discussion
This study highlights the concerning prevalence of E. coli isolated from Sonali chicken meat, characterized by extensive AMR and the presence of diverse β-lactamase genes.
In this study, 68.31% of 390 meat swab samples tested positive for E. coli, consistent with a previous study, which reported a 63.5% prevalence in broiler and layer chicken meat swabs27. Comparable findings were reported in Sri Lanka at 65.73%23, while lower prevalence rates ranging from 49.02% to 53% were also reported in other studies28,29. In contrast, contamination levels were as low as 25% in poultry meat in Thailand30and as high as 83% in retail poultry products in Spain31. A meta-analysis further estimated a pooled prevalence of 73% across poultry in South Asia32. These variations likely reflect differences in sample sources, sampling methods, hygienic conditions of retail shops33, and slaughtering processes34,35
Our findings revealed that 7.89% of the E. coli isolates were classified as EPEC. This aligns with the 7.5% prevalence reported in raw chicken meat in Iran36, although higher rates (24.5%) have been reported in diarrheagenic E. coli from food products37. Similarly, studies reported EPEC rates of 26.76%, 20.5%, and 20% in broiler, pork, and beef meat, respectively38,39. The presence of EPEC in Sonali chicken meat underscores its zoonotic potential, posing a risk of severe enteric diseases in humans40.
Antibiotic susceptibility testing revealed 100% resistance to ampicillin, consistent with earlier reports of 89.1% and 89.6% resistance in Bangladesh41,42. Conversely, resistance to ampicillin was significantly lower (14.1% ) in Australia43, reflecting regional differences in antibiotic usage. High resistance rates to other antibiotics, including erythromycin (87.59%), cefpodoxime (84.59%), ceftazidime (83.08%), and co-trimoxazole (74.44%) are also aligned with previous studies27,28,44. Importantly, susceptibility was highest for amoxicillin-clavulanate (86.57%), followed by ceftriaxone (71.05%), ciprofloxacin (71.05%), levofloxacin (73.05%), and gentamicin (62.03%), which aligns with similar observations44,45.
Our study found that 41.73% of the E. coli isolates were ESBL producers. The blaTEM gene was the most prevalent (63.06%), followed by blaCTX-M-2a (60.36%), blaOXA-1 (40.54%), blaCTX-M-1 (28.83%), and blaSHV (27.03%). Previous studies reported varying prevalence rates, with one study detecting blaTEM in all ESBL-positive isolates, while blaCTX-M-1 was absent41. Similarly, blaCTX-M (76.4%) and blaTEM(45.3%) were the most common ESBL genes in retail meats46. The co-occurrence of ESBL genes, observed in 54.95% of isolates, particularly the combination of blaTEM, blaCTX-M-2a, and blaOXA-1 in 21.62%, exacerbates the resistance problem.
The present investigation reported that AmpC β-lactamase genes were present in 27.07% of isolates, all non-EPEC strains. Comparable rates (39.5%) of blaCMY-2 have been reported in poultry meat47, with similar prevalence observed in human clinical settings48,49.
Notably, Metallo-β-lactamase (MBL) genes, specifically blaNDM-1, were detected in 9.02% of the isolates, representing the first report of this gene from poultry meat in Bangladesh. In comparison, a higher prevalence (14.2%) was documented in chicken meat from Pakistan50. Furthermore, 2.26% of the isolates co-harbored MBL and ESBL genes, highlighting the risk of complex resistance mechanisms that could limit treatment options.
The high prevalence of E. coli and multidrug resistance observed in this study underscores the urgent need for prudent antibiotic use in poultry farming. Contamination of meat by E. coli may result from poor hygienic practices during slaughter and processing, highlighting the necessity for strict hygiene protocols to mitigate public health risks. This study provides a comprehensive analysis of antibiogram profiles and resistance gene prevalence in EPEC and non-EPEC isolates, offering valuable insights to inform targeted interventions for reducing zoonotic transmission.
However, we acknowledge some limitations in our study. First, the reliance on phenotypic methods for ESBL detection, which may have overlooked certain ESBL variants, highlighting the need for sequencing to confirm the identity and integrity of β-lactamase resistance genes. Additionally, while PCR-based detection identified key resistance genes, lack of whole-genome sequencing for resistance profiling limits the ability to comprehensively assess the genetic basis of resistance, which could provide deeper insights into the transmission potential, and co-occurring resistance mechanisms. Moreover, this study was conducted in Narsingdi district, which may limit the generalizability to other regions or countries with different slaughtering and hygienic practices in retail shops. Future research should focus on tracing E. coli transmission pathways from poultry farms to slaughterhouses to consumers, expanding AMR surveillance across multiple districts, and promoting rational antibiotic use in poultry farming. Additionally, implementing strict hygiene measures during poultry processing and establishing nationwide surveillance systems would be crucial in monitoring antimicrobial resistance and resistance gene dissemination in poultry production.
Conclusion
This study highlights the public health implications of AMR in E. coli isolated from Sonali chicken meat in Bangladesh. The detection of multidrug resistance, and diverse β-lactamase genes including blaTEM, blaCTX-M-2a, and blaOXA-1, underscores the complexity of resistance mechanisms and their potential for horizontal gene transfer within the food chain. The exclusive identification of blaCMY and blaNDM-1 resistance genes in non-EPEC isolates, further highlights the diversity of resistance patterns among pathotypes. These findings emphasize the urgent need for integrated measures such as strengthening antimicrobial stewardship programs, enhanced surveillance, stricter antibiotic regulations, and improved hygienic practices in poultry processing to mitigate the dissemination of resistant bacteria within the food chain. By addressing these gaps, we can better safeguard public health and ensure the responsible use of antibiotics in food production systems.
Data availability
The datasets used and/or analyzed during the current study are available from the corresponding author upon reasonable request.
References
WHO. 10 global health issues to track in 2021. 2021 [cited 2024 11 November]; Available from: https://www.who.int/news-room/spotlight/10-global-health-issues-to-track-in-2021.
Mulchandani, R. et al. Global trends in antimicrobial use in food-producing animals: 2020 to 2030. PLOS Glob. Public Health 3(2), e0001305 (2023).
Van Boeckel, T. P. et al. Global trends in antimicrobial resistance in animals in low- and middle-income countries. Science https://doi.org/10.1126/science.aaw1944 (2019).
Martínez-Álvarez, S. et al. Antimicrobial resistance in escherichia coli from the broiler farm environment, with detection of SHV-12-producing Isolates. Antibiotics (Basel). 11(4), 444 (2022).
Gyles, C. and J. Prescott, Pathogenesis of Bacterial Infections in Animals, Fourth Edition. 3–14 (2010)
Mare, A. D. et al. Enteropathogenic escherichia coli—A summary of the literature. Gastroenterology Insights 12(1), 28–40 (2021).
Mora, A. et al. Poultry as reservoir for extraintestinal pathogenic escherichia coli O45:K1:H7-B2-ST95 in humans. Vet. Microbiol. 167(3–4), 506–512 (2013).
Dutta, T. K. et al. Detection & characterization of Shiga toxin producing Escherichia coli (STEC) & enteropathogenic Escherichia coli (EPEC) in poultry birds with diarrhoea. Indian J. Med. Res. 133(5), 541–545 (2011).
Zabiszak, M. et al. Complexes of β-lactam antibiotics and their Schiff-base derivatives as a weapon in the fight against bacterial resistance. Coord. Chem. Rev. 493, 215326 (2023).
Cag, Y. et al. Resistance mechanisms. Ann. Transl. Med. 4(17), 326 (2016).
Jena, J. et al. Prevalence of TEM, SHV, and CTX-M genes of extended-spectrum β-lactamase-producing Escherichia coli strains isolated from urinary tract infections in adults. 3 Biotech 7(4), 244 (2017).
Bush, K. & Bradford, P. A. β-Lactams and β-Lactamase Inhibitors: An Overview. Cold Spring Harb. Perspect. Med. 6(8), a025247 (2016).
Evans, B. A. & Amyes, S. G. OXA β-lactamases. Clin. Microbiol. Rev. 27(2), 241–263 (2014).
Cantón, R., González-Alba, J. M. & Galán, J. C. CTX-M Enzymes: Origin and diffusion. Front. Microbiol. 3, 110 (2012).
Böhm, M. E. et al. A novel, integron-regulated Class C β-Lactamase. Antibiotics (Basel) 9(3), 123 (2020).
Ramatla, T. et al. “One Health” perspective on prevalence of co-existing extended-spectrum β-lactamase (ESBL)-producing Escherichia coli and Klebsiella pneumoniae: a comprehensive systematic review and meta-analysis. Ann. Clin. Microbiol. Antimicrob. 22(1), 88 (2023).
Hamid, D. M. et al. Status of poultry industry in Bangladesh and the role of private sector for its development. Asian J. Poult. Sci. 11, 1–13 (2016).
Masud, A. A. et al. Drivers of antibiotic use in poultry production in Bangladesh: Dependencies and dynamics of a patron-client relationship. Front. Vet. Sci. https://doi.org/10.3389/fvets.2020.00078 (2020).
BBS. Agriculture Census 2019. Structure of Agricultural Holdings and Livestock & Fisheries. 2019 [cited 2025 02 February]; Available from: https://bbs.portal.gov.bd/sites/default/files/files/bbs.portal.gov.bd/page/c645bd51_3cb5_4f53_86f9_7d29244caa4e/2022-12-26-08-36-394361bc904a7651ef763a4ff8033b67.pdf.
Islam, M. S. & Hossen, M. F. Status of sonali chicken farming in rajshahi division, Bangladesh: An updated survey. IAR J. Agric. Res. Life Sci. 2(3), 20–29 (2021).
Tipu, J. et al. Prevalence and pathological affections of infectious diseases in sonali chickens in the kishoreganj district of bangladesh. Adv. Anim. Vet. Sci 9(9), 1317–1323 (2021).
Habib, I. et al. Enumeration, antimicrobial resistance and genomic characterization of extended-spectrum β-lactamases producing escherichia coli from supermarket chicken meat in the United Arab Emirates. Int. J. Food Microbiol. 398, 110224 (2023).
Ranasinghe, R. A. S. S. et al. Prevalence and antimicrobial resistance of escherichia coli in chicken meat and edible poultry organs collected from retail shops and supermarkets of North Western Province in Sri Lanka. J. Food Qual. 2022(1), 8962698 (2022).
Cheesbrough, M., Medical laboratory manual for tropical countries. Vol. II. 1st ed. 1985, London: Tropical Health Technology : Butterworths.
CLSI. M100 Performance Standards for Antimicrobial Susceptibility Testing. 2020 [cited 2024 15 October]; Available from: https://www.nih.org.pk/wp-content/uploads/2021/02/CLSI-2020.pdf.
Organization, W.H., WHO Medically Important List. A Risk Management Tool for Mitigating Antimicrobial Resistance Due to Non-Human Use. World Health Organization: Geneva, Switzerland, 2023.
Rahman, M. M. et al. Isolation and molecular characterization of multidrug-resistant escherichia coli from chicken meat. Sci. Rep. 10(1), 21999 (2020).
Rahman, M. et al. Antimicrobial resistance of escherichia coli isolated from milk, beef and chicken meat in Bangladesh. Bangladesh J. Vet. Med. 15, 141 (2018).
Faruque, M. O. et al. Bacteriological analysis and public health impact of broiler meat: A study on Nalitabari Paurosova, Sherpur. Bangladesh Adv. Microbiol. 9(7), 581–601 (2019).
Akbar, A. et al. Presence of Escherichia coli in poultry meat: A potential food safety threat. Int. Food Res. J. 21(3), 941 (2014).
García-Béjar, B. et al. High prevalence of antibiotic-resistant Escherichia coli isolates from retail poultry products in Spain. Animals 11(11), 3197 (2021).
Dawadi, P., Bista, S. & Bista, S. Prevalence of colistin-resistant escherichia coli from poultry in South Asian developing Countries. Vet. Med. Int. 2021(1), 6398838 (2021).
Eyi, A. & Arslan, S. Prevalence of Escherichia coli in retail poultry meat, ground beef and beef. Med. Weter 68(4), 237–240 (2012).
Sebsibe, M. A. & Asfaw, E. T. Occurrence of multi-drug resistant Escherichia coli and Escherichia coli O157: H7 in meat and swab samples of various contact surfaces at abattoir and butcher shops in Jimma town, Southwest district of Ethiopia. Infect. Drug Resist. 13, 3853–3862 (2020).
Cohen, N. et al. Comparative study of microbiological quality of raw poultry meat at various seasons and for different slaughtering processes in Casablanca (Morocco). J. Appl. Poultry Res. 16(4), 502–508 (2007).
Zarei, O. et al. The prevalence of shiga toxin-producing escherichia coli and enteropathogenic escherichia coli isolated from raw chicken meat samples. Int. J. Microbiol. 2021(1), 3333240 (2021).
Fallah, N. et al. Occurrence, pathotypes, and antimicrobial resistance profiles of diarrheagenic Escherichia coli strains in animal source food products from public markets in Mashhad. Iran. Food Control 121, 107640 (2021).
Lee, G. Y. et al. Prevalence and classification of pathogenic Escherichia coli isolated from fresh beef, poultry, and pork in Korea. Int. J. Food Microbiol. 134(3), 196–200 (2009).
Alonso, M. Z. et al. Enteropathogenic (EPEC) and Shigatoxigenic Escherichia coli (STEC) in broiler chickens and derived products at different retail stores. Food Control 23(2), 351–355 (2012).
Buskirk, A. D. et al. Mucosal immune profiles associated with diarrheal disease severity in shigella-and enteropathogenic escherichia coli-infected children enrolled in the global enteric multicenter study. MBio 13(4), e00538-e622 (2022).
Parvin, M. S. et al. Antimicrobial resistance pattern of escherichia coli isolated from frozen chicken meat in Bangladesh. Pathogens 9(6), 420 (2020).
Musa, L. et al. Antimicrobial susceptibility of escherichia coli and ESBL-producing escherichia coli diffusion in conventional, organic and antibiotic-free meat chickens at slaughter. Animals 10(7), 1215 (2020).
Abraham, S. et al. Escherichia coli and Salmonella spp. isolated from Australian meat chickens remain susceptible to critically important antimicrobial agents. PLoS ONE 14(10), e0224281 (2019).
Rafiq, K. et al. Antimicrobial resistance profile of common foodborne pathogens recovered from livestock and poultry in Bangladesh. Antibiotics 11(11), 1551 (2022).
Ema, F. A. et al. Isolation, identification, and antibiogram studies of Escherichia coli from ready-to-eat foods in Mymensingh, Bangladesh. Vet. World 15(6), 1497 (2022).
Guo, S. et al. Prevalence and genomic analysis of ESBL-producing Escherichia coli in retail raw meats in Singapore. J. Antimicrob. Chemother. 76(3), 601–605 (2021).
Tansawai, U. et al. Occurrence of extended spectrum β-lactamase and AmpC genes among multidrug-resistant escherichia coli and emergence of ST131 from poultry meat in Thailand. Food Control 84, 159–164 (2018).
Doi, Y. et al. Extended-spectrum and CMY-type b-lactamase-producing Escherichia coli in clinical samples and retail meat from Pittsburgh, USA and Seville Spain. Clin. Microbiol. Infect. 16(1), 33–38 (2010).
Pehlivanlar Önen, S. et al. Prevalence of β-lactamase producing Escherichia coli from retail meat in Turkey. J. Food Sci. 80(9), M2023–M2029 (2015).
Younas, M. et al. Multidrug resistant carbapenemase-producing Escherichia coli from chicken meat reveals diversity and co-existence of carbapenemase encoding genes. Pak. Vet. J 39, 241–245 (2019).
Kahali, S. et al. Molecular epidemiology of diarrhoeagenic Escherichia coli associated with sporadic cases and outbreaks of diarrhoea between 2000 and 2001 in India. Eur. J. Epidemiol. 19(5), 473–479 (2004).
Olesen, I., Hasman, H. & Aarestrup, F. M. Prevalence of beta-lactamases among ampicillin-resistant escherichia coli and Salmonella isolated from food animals in Denmark. Microb. Drug Resist. 10(4), 334–340 (2004).
Mulvey, M. R. et al. Characterization of the first extended-spectrum beta-lactamase-producing Salmonella isolate identified in Canada. J. Clin. Microbiol. 41(1), 460–462 (2003).
Eckert, C. et al. Dissemination of CTX-M-type beta-lactamases among clinical isolates of Enterobacteriaceae in Paris France. Antimicrob. Agents Chemother. 48(4), 1249–1255 (2004).
Drieux, L. et al. Phenotypic detection of extended-spectrum β-lactamase production in Enterobacteriaceae: Review and bench guide. Clin. Microbiol. Infect. 14, 90–103 (2008).
Net, M.V. Resistance to beta- lactam antibiotics. 2005 [cited 2024 11 November]; Available from: https://mobil.bfr.bund.de/cm/343/med_vet_net_news_volume_2_issue_2.pdf.
Ogutu, J. O. et al. Development of a multiplex PCR system and its application in detection of blaSHV, blaTEM, blaCTX-M-1, blaCTX-M-9 and blaOXA-1 group genes in clinical Klebsiella pneumoniae and escherichia coli strains. J. Antibiot. (Tokyo) 68(12), 725–733 (2015).
Zhao, S. et al. Characterization of Salmonella enterica serotype newport isolated from humans and food animals. J. Clin. Microbiol. 41(12), 5366–5371 (2003).
Islam, M. A. et al. Emergence of multidrug-resistant NDM-1-producing Gram-negative bacteria in Bangladesh. Eur. J. Clin. Microbiol. Infect. Dis. 31(10), 2593–2600 (2012).
Acknowledgements
We would like to acknowledge the Sylhet Agricultural University Research System (SAURES) for their support to facilitate this study.
Funding
This study was supported by World’s Poultry Science Association-Bangladesh Branch (WPSA-BB) “Open Research Grants 2023”.
Author information
Authors and Affiliations
Contributions
Conceptualization, methodology, investigation, data curation, formal analysis, resources, writing-original draft preparation: M.N., M.A., J.H.T., O.I., A.R., and F.M.A.H.; editing and writing-review: M.A., J.H.T., O.I., M.A.M., M.M.R., A.H.M.K., and M.N.; project administration: M.N.; funding achievement: A.H.M.K. and M.N. All authors have read and approved the published version of the manuscript.
Corresponding author
Ethics declarations
Competing interests
The authors declare no competing interests.
Ethical approval
The animal handling in this study was conducted in compliance with the current legislation of Bangladesh (Cruelty to Animals Act 1920, Act No. I of 1920, Government of the People’s Republic of Bangladesh). The study was approved by the Ethics Committee of Sylhet Agricultural University, Bangladesh.
Additional information
Publisher’s note
Springer Nature remains neutral with regard to jurisdictional claims in published maps and institutional affiliations.
Supplementary Information
Rights and permissions
Open Access This article is licensed under a Creative Commons Attribution-NonCommercial-NoDerivatives 4.0 International License, which permits any non-commercial use, sharing, distribution and reproduction in any medium or format, as long as you give appropriate credit to the original author(s) and the source, provide a link to the Creative Commons licence, and indicate if you modified the licensed material. You do not have permission under this licence to share adapted material derived from this article or parts of it. The images or other third party material in this article are included in the article’s Creative Commons licence, unless indicated otherwise in a credit line to the material. If material is not included in the article’s Creative Commons licence and your intended use is not permitted by statutory regulation or exceeds the permitted use, you will need to obtain permission directly from the copyright holder. To view a copy of this licence, visit http://creativecommons.org/licenses/by-nc-nd/4.0/.
About this article
Cite this article
Ali, M., Tipu, J.H., Islam, O. et al. Molecular characterization of multidrug-resistant and extended-spectrum beta-lactamase (ESBL)-producing Escherichia coli isolated from Sonali chicken meat in Bangladesh. Sci Rep 15, 25350 (2025). https://doi.org/10.1038/s41598-025-96073-9
Received:
Accepted:
Published:
Version of record:
DOI: https://doi.org/10.1038/s41598-025-96073-9